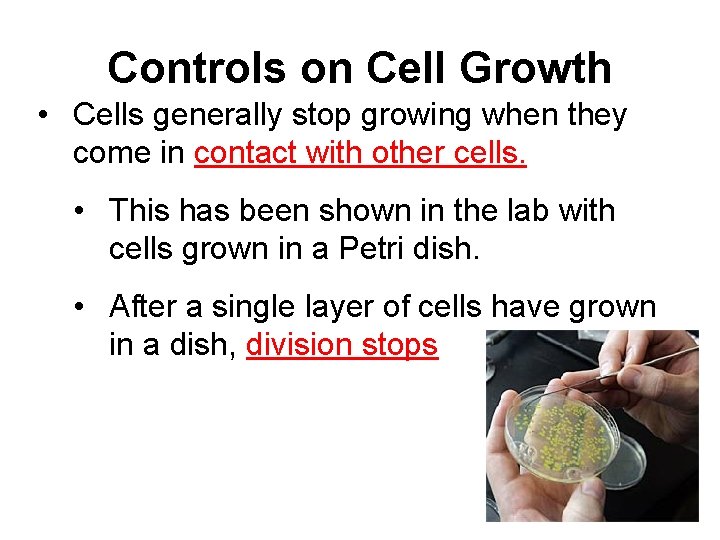
Controls on Cell Growth • Cells generally stop growing when they come in contact

1 Cell Growth and Mitosis Notes How do





























































- Slides: 61

1 - Cell Growth and Mitosis Notes

How do living things grow? Limits to cell growth controls the cell’s • DNA “overload” – DNA ____ activities. • The bigger the cells, the more activity. DNA cannot keep up with the needs of the cell.

How do living things grow? • Material exchange – Food, H 20, and O 2 enter through the cell membrane, while waste products leave. • The bigger the cell, the more food, H 20, and O 2 are needed, while more waste is produced

• Surface area to volume ratio: The amount of surface area (perimeter of the cell) compared to the amount of space that makes up the cell.

Conclusions from Cell Size and Diffusion Lab • Volume increases at a faster rate than surface area. • The cell has an increased demand for food, water and oxygen and a greater production of waste, but it has a decrease in the area where food can enter and waste can leave. • How can a cell avoid these problems? Divide!! OMG!

Rates of Cell Division Escherechia coli, a single celled bacterium 17 minutes • Divides in _______ 25 individuals ~85 generations; 3. 9 x 10 • In 24 hrs __________ generations; 2. 9 X 1076 individuals • In 72 hrs ~254 __________

Chromosomes • • Contain hereditary genetic information Only visible during cell division Made of DNA Humans have 46 chromosomes

Chromosomes are replicated before cell division (which is when they become visible during cell division)

Chromatids: Two identical strands of a chromosome that are visible during cell division Centromere: The area where the two “sister” chromatids are held together

The Cell Cycle • The series of events that cells go through as they grow and divide. • The cell grows, prepares for division, and divides into 2 daughter cells, each of which begins the cycle again.


The cycle is characterized by a series of phases: Gap II G 2 Synthesis S Gap I G 1 Prophase Metaphase M - Phase Anaphase Telophase Cytokinesis

Interphase • The period in between cell divisions • The longest phase of the cell cycle.

Interphase is divided into three subphases: • G 1 (Gap 1) Cellular growth & development • S (Synthesis) DNA replication • G 2 (Gap 2) Organelles are synthesized; The shortest period of interphase

Cell Division: Mitosis and Cytokinesis (M-Phase) 1) Mitosis: Process where the nucleus divides into two nuclei, each with the same chromosomes as the parent cell

Cell Division: Mitosis and Cytokinesis (M-Phase) 2) Cytokinesis: Process by which the cytoplasm divides, forming 2 distinct daughter cells

Cell Division: Mitosis and Cytokinesis (M-Phase) Mitosis: The nucleus divides into two nuclei through a four-phase process: Prophase Metaphase Anaphase Telophase

Prophase: • First and longest phase • Chromosomes become visible • Centrioles (in animals only) separate and migrate to opposite poles • Spindle forms (a mesh-like structure) • Nuclear membrane breaks down


Metaphase: • Chromosomes line up along cell equator • Spindles attach to centromere of chromosomes

Anaphase: • Sister chromatids separate • Chromosomes move toward opposite poles of cell

Telophase: • Chromosomes gather at opposite ends of the cell • Chromosomes become less visible by uncoiling • Nuclear envelope (membrane) begins to form


Cytokinesis

Cytokinesis: • Immediately follows mitosis • Cytoplasm is divided into two cells • In animals, a cleavage furrow develops, pinching the cytoplasm into two parts. • In plants, a cell plate forms across the middle of the cells and separates the two parts.


Mitosis Animations & Videos Mitosis & Cytokinesis 2: 45 Mitosis & Cell Cycle 6: 11

Mitosis Animation

Mitosis Animation

Controls on Cell Growth: • Some cells rarely divide – Ex: Cells of the heart and nervous system • Some cells divide rapidly and often • Ex: Cells of the skin & digestive system
Controls on Cell Growth • Cells generally stop growing when they come in contact with other cells. • This has been shown in the lab with cells grown in a Petri dish. • After a single layer of cells have grown in a dish, division stops

Controls on Cell Growth • The cell has controls in place that tell the cells when it is appropriate to divide: cyclins • Example: Skin and bone cells rapidly divide after injury (cut or broken bone) until injury is healed.

What happens if these controls are turned off or are no longer affective? Uncontrolled cell growth: Cancer: A disorder in which cells have lost the ability to control their own rate of growth. Example: In the lab, cancerous cells no longer stop growing when they come in contact with other cells Cancer and Mitosis Simulation Normal Cell to a Cancer Cell


Tumor: mass of body cells

Tumor: mass of body cells Benign: stays at original site (not harmful) Malignant: spreads into other tissues, interrupting organ functions Metastasis occurs when cancer cells are spread through the circulatory system and grow at a new site. How Cancer Spreads Video 1: 33 min

Cancers are named according to where they originate from: • Carcinoma: start in the internal or external covering (epithelial) • Example: Skin or lining of the intestine (basal cell carcinoma-most common skin cancer)

Cancers are named according to where they originate from: Sarcoma: Start in supporting tissue (bone, cartilage, muscle, fat) Ex: bone (osteosarcoma)


Cancers are named according to where they originate from: Leukemia: Start in blood-forming tissue (bone marrow, spleen) Ex: Acute lymphocytic leukemia

Cancers are named according to where they originate from: Lymphoma: start in lymph nodes Ex: Hodgkin’s lymphoma

How is it possible for a child to get information from both parents without doubling the chromosome number? MEIOSIS

How is it possible for a child to get information from both parents? Chromosome Number • Diploid: a cell that contains homologous chromosomes - one set of chromosomes from each parent; found in body cells

How is it possible for a child to get information from both parents? • Homologous Chromosomes: Matching chromosomes o One set from the male parent and one set from the female parent o In humans, 23 chromosomes come from the male (in sperm cell) and 23 chromosomes come from the female (in egg cell) • Diploid Symbol: 2 N Examples: Human: 2 N = 46 Drosophila: 2 N = 8

Cells that contain one set of chromosomes (sex cells) Haploid Symbol: N Examples: Humans: N = 23 Drosophila: N = 4

• Meiosis: Process of reduction division. • The number of chromosomes is cut in half because the homologous chromosomes are separated from one another. • Makes sex cells.

How Meiosis Works

Interphase: Same as in mitosis, chromosomes are duplicated.

Meiosis I: First round of cell division. Includes Prophase 1, Metaphase 1, Anaphase 1, Telophase 1 Prophase 1: • Chromosomes become visible • Homologous chromosomes match up in tetrads • Centrioles separate, spindle forms • Crossing over occurs Tetrad

Metaphase 1: • Spindle fibers attach to centromeres • Homologous pairs of chromosomes line up along the center of the cell

Anaphase 1: • Spindle fibers pull homologous chromosomes apart

Telophase 1: • Cell starts to pinch together • Chromosmes begin to uncoil & nuclear envelope reappears

Prophase 2: • Starts with two haploid (N) cells • Chromosomes become visible • Nuclear envelope disappears

Metaphase 2: • Spindles form • Chromosomes line up in the middle (similar to metaphase in mitosis)

Anaphase 2: • Sister chromatids separate & move to opposite ends of the cell

Telophase 2: • Chromosomes uncoil • Nuclear envelope reappears • 4 genetically unique haploid (N) cells created

Telophase 2:

Males versus Females: Meiosis Males: • Produce 4 equally usable, genetically unique haploid cells (sperm) Female: • Produces 4 unequal haploid cells – 1 usable ovum (egg) and 3 unusable polar bodies


Mitosis Versus Meiosis MITOSIS MEIOSIS Type of cells occurs in # of Cells produced Body cells Germ cells Type of cell produced Diploid Haploid Cells produced compared to original cell Genetically identical Genetically different Number of divisions Crossing over occurs 2 1 No 4 2 Yes

Meiosis Videos • Meiosis Square Dance - 3: 21 min • Best Meiosis Video Ever - 8: 37 min • Meiosis Crash Course - 11: 43 min